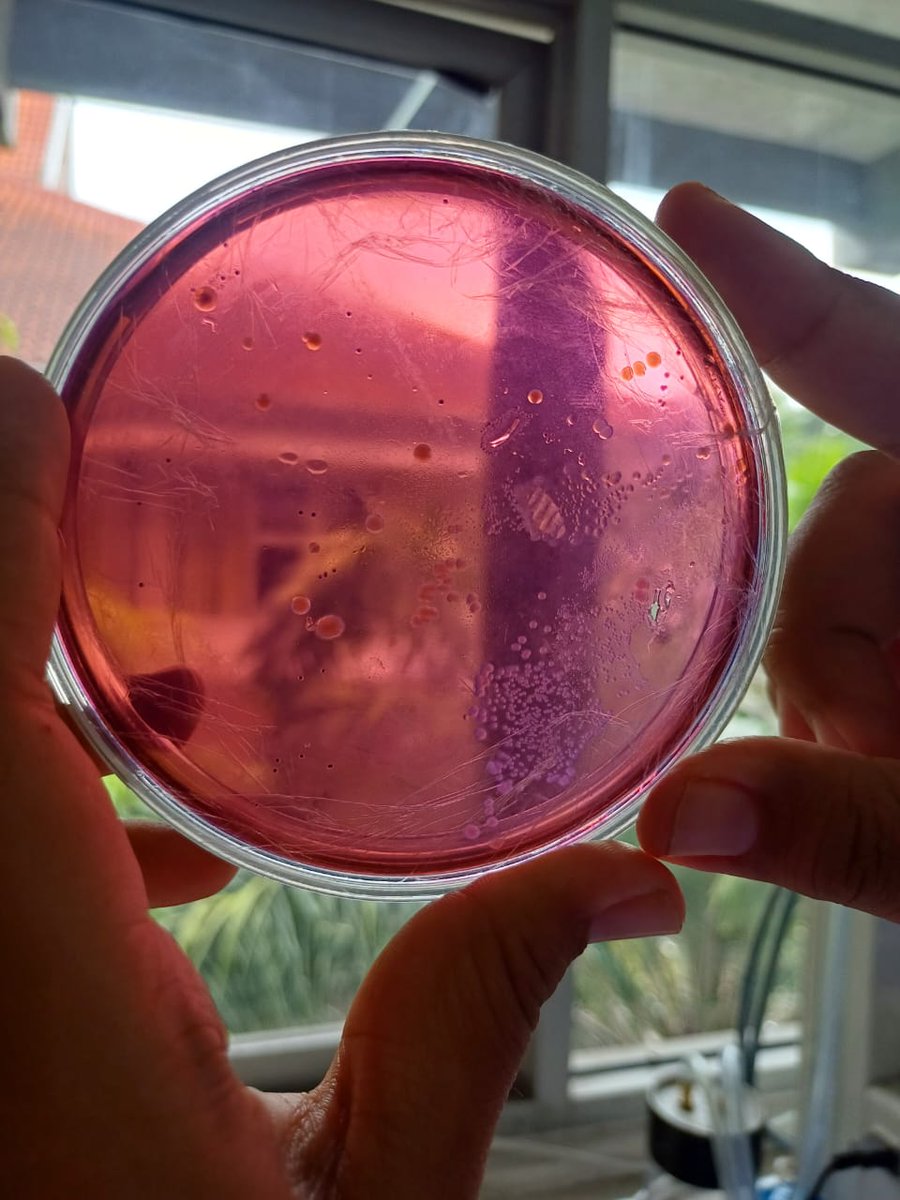
scientissts's tweet image. selamat datang maba bioteknologi um 2025, inilah kehidupan kalian nanti

hAna
@scientissts
idgaf how much i have to study, cry, and struggle. im going to have the job i want, the money i want, the life i want
You might like
selamat datang maba bioteknologi um 2025, inilah kehidupan kalian nanti

APASIHHH KENAPA SEMUA ORANG DI MUKA BUMI INI PACARAN SEBEELLLLL
walaupun ga dapet univ nya tapiii univ yang aku dapetin juga seruuu seruuu bangettt dan di prodi impian aku juga jadii ga nyesel pokoknya cape tapi seruuuu!!!
kakak kakak 24 yang sekarang udh ngejalanin kuliah, how’s it going this far? ngerasa salah jurusan ga? ptn!
iya lagi kocak
stop impulsive buying 🫵🫵🫵, lo itu anak kos 😥😥😥 .... stop impulsive buying 🫵🫵🫵, lo itu anak kos 😥😥😥 .... stop impulsive buying 🫵🫵🫵, lo itu anak kos 😥😥😥.... stop impulsive buying 🫵🫵🫵, lo itu anak kos 😥😥😥 ....
United States Trends
- 1. Good Sunday N/A
- 2. Cooks N/A
- 3. Muhammad Qasim N/A
- 4. #MeAndTheeSeriesAfterParty N/A
- 5. #INDvsNZ N/A
- 6. #sundaymotivation N/A
- 7. #SundayThoughts N/A
- 8. Sunday Funday N/A
- 9. Congratulations Jack N/A
- 10. Gene N/A
- 11. Face the Nation N/A
- 12. Beane N/A
- 13. #sundayvibes N/A
- 14. Calvin Johnson N/A
- 15. Blessed Sunday N/A
- 16. The NFL N/A
- 17. Virginia N/A
- 18. Lord Jesus Christ N/A
- 19. Stidham N/A
- 20. McDermott N/A
You might like
-
 berlianaa🌷⅖
berlianaa🌷⅖
@bungacintapsiko -
 lupi
lupi
@lupiaaw -
 syl udah jadi maba
syl udah jadi maba
@swcoi -
 f ❦
f ❦
@2sylvetris -
 toz
toz
@kyeitoz -
 Reeru ✩°。📔𓏲⋆.🏅𖦹 ₊˚
Reeru ✩°。📔𓏲⋆.🏅𖦹 ₊˚
@dowxze -
 tomatt 🩷💚
tomatt 🩷💚
@tomat_enakk -
 tifa²⁶ free tag to
tifa²⁶ free tag to
@avicennaesculap -
 shakey
shakey
@kulomiee -
 cit²⁶ 🇵🇸 | agit
cit²⁶ 🇵🇸 | agit
@cdrvit -
 saa
saa
@shyarchivee -
 chaa
chaa
@maarjoriees -
 ifa²⁶
ifa²⁶
@43paths -
 ren
ren
@urweenyy -
 riria 🦋²⁴ | 🍉🍉 🇵🇸
riria 🦋²⁴ | 🍉🍉 🇵🇸
@historiria
Something went wrong.
Something went wrong.
























































































